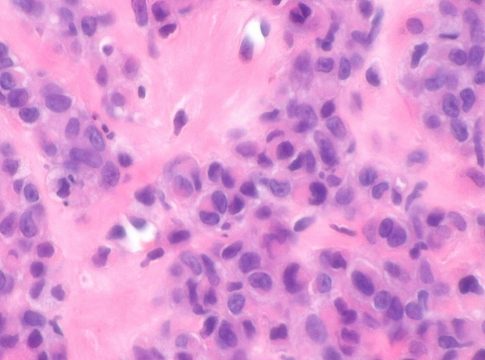

Comprobar a menudo nuestro cuerpo para detectar bultos extraños es una buena idea. El cuerpo puede tener diferentes tipos de tumores y el lipoma es un tumor de tipo benigno que se da en el tejido blando. Estos se dan con más frecuencia a medida que la edad es más avanzada y son nódulos móviles con un crecimiento lento. A diferencia de los tumores malignos, los lipomas tienen una apariencia exterior normal y pueden aumentar de grosor con el paso del tiempo.
¿Por dónde suelen aparecer los lipomas?

Los lipomas son usuales en muchas partes del cuerpo humano, pero de manera más habitual se suelen encontrar en las regiones que están próximas a las extremidades y al tronco. Además, estos suelen ser tumores grandes e intramusculares que resultan fáciles de localizar y están bien delimitados.
Un lipoma puede llegar a tener un tamaño de entre los 2 centímetros y los 10 centímetros aunque pueden llegar a tener mayor tamaño si el lipoma es más profundo e intramuscular. Hay personas que pueden desarrollar varios lipomas a la vez y a este fenómeno se le llama lipomatosis.
¿Cuándo es más común tenerlos y cuáles son sus causas?

Los lipomas, como comentamos anteriormente, se suelen dar en una edad más adulta entre los 40 y los 60 años. Es muy raro encontrar un lipoma en una persona que tenga menos de 20 años. Sin embargo, en términos generales es muy habitual encontrarlos ya que es el más común de todos los tumores que se localizan en los tejidos blandos.
No se sabe con claridad la causa de los lipomas, aunque sí se sabe que influye la existencia de casos previos en la familia por lo que los factores genéticos deben tener algo que ver. Si tu madre o padre los tienen, es probable que tú también puedas tener alguno.
Las mujeres son más propensas a tener un lipoma y si su familia tiene antecedentes de tenerlos entonces es mucho más probable que se padezcan. No obstante, esto no quiere decir que te salgan por cuestión genética únicamente. Hay personas que los pueden tener y no es por causa hereditaria.
¿Cómo pueden clasificarse los lipomas?

Hay diferentes tipos de lipomas que debemos conocer. El lugar donde suelen aparecer son superficiales, es decir, subcutáneos como son lesiones blandas, pequeñas y móviles además de ser indoloras. Al comienzo pueden pasar desapercibido, pero con el tiempo van creciendo y se hacen evidentes.
Tipos de lipomas

- El lipoma convencional. Este puede aparecer dentro del tejido subcutáneo, también se pueden dar casos donde aparecen en los tejidos blandos profundos o en las superficies del hueso.
- El lipoma profundo. Este aparece dentro o entre las fibras musculares esqueléticas llamándose también lipoma intramuscular.
- El lipoma intramuscular. Este es el que hace que el músculo esquelético esté involucrado haciendo que aparezcan en varios lugares como puede ser en el tronco, en el cuello y en la cabeza.
- El lipoma intermuscular. Este aparece en la pared abdominal anterior con más frecuencia.
- El lipoma arborescens. A este también se lo llama proliferación lipomatosa vellosa de la membrana sinovial. Tiene como principal característica la infiltración de grasa del tejido conectivo subsinovial.
- El lipoma retroperitoneal. Estos son poco frecuentes y se requiere de confirmación molecular.
La diferente clasificación de los lipomas

Para clasificar un lipoma se debe prestar atención a las características moleculares distintivas y también a las morfológicas. A continuación os dejamos las más importantes.
- Lipoma convencional. Este es un lipoma que tiene masa encapsulada y es el que se da con mayor frecuencia.
- Fibrolipoma. Este lipoma tiene un tejido adiposo con más fibra.
- Angiolipoma. Está formado por adipocitos maduros que tienen vasos sanguíneos anormales.
- Mielolipoma. Este está formado por tejido adiposo maduro y además tiene elementos hermatopoyéticos variados.
- Lipoma de células fusiformes. Este está compuesto por la proliferación de adipocitos maduros, célular fusiformes y a veces células gigantes multinucleares.
¿Cómo es el diagnóstico de un lipoma?

Lo primero que se debe hacer es un examen físico aunque si el diagnóstico se complica lo usual es llevarlo al dermatólogo para que pueda hacer un examen más detallado. Sin embargo, este no es el único diagnóstico ya que se pueden realizar otro tipo de procedimientos.
Entre los procedimientos más frecuentes se encuentra la radiografía preoperatoria, el análisis de diagnóstico por imágenes, las resonancias magnéticas etc. En el caso de que el lipoma sea grande, tenga un aspecto inusual o sea más profundo de lo normal, se puede realizar una exploración por TC que significa 'Tomografía computarizada'.
Otros métodos de diagnóstico son la ecografía que se parece a la resonancia magnética y que ha tenido mucho éxito a la hora de diferenciar los lipomas. Sin embargo, no se puede confiar en este procedimiento al 100%. Luego se puede realizar una biopsia mediante aspiración con aguja fina para luego llevarlo a un laboratorio y que realicen un análisis más exhaustivo. Esto se debe a que el lipoma podría terminar siendo un cáncer.
¿Hay lipomas que presenten riesgos?

Los lipomas suelen presentarse en adultos entre los 40 y 60 años. Sin embargo, a veces se pueden presentar en niños aunque es algo muy raro. Si se presentar en niños puede indicar que este tiene obesidad. También hay una serie de trastornos asociados.
- El síndrome de Gardner donde hay mayor frecuencia de desarrollar lipomas múltiples.
- Personas que tienen enfermedad de Dercum. Este se caracteriza por formar bultos dolorosos en el tronco, en los hombres, los brazos y las piernas.
- Síndrome de Cowden. Este presenta hematomas en la piel, en la glándula tiroides, en las membranas mucosas y en el tejido mamario.
Por lo tanto, si tenemos un lipoma debemos prestar atención a si crece rápido y en exceso, si tiene un diámetro de más de cinco centímetros, si está en las zonas de las extremidades, en la ingle, en el escroto o en la pared abdominal o si es profundo o si invade el nervio o el hueso. Estos síntomas son signos de alarma aunque siempre debemos ir al médico para que nos ayude a analizarlo.